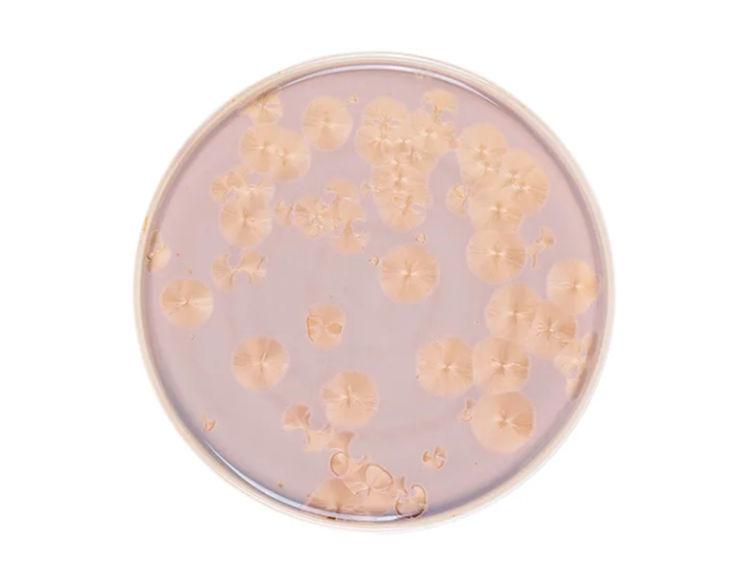

Тарелка обеденная Фрост с бортом, 26 см, коричневая ZH003-Y191/B Royal Charm
Артикул: ZH003-Y191/B
1 554
Временно нет в наличии
Похожие товары:
ОписаниеХарактеристикиОтзывыГарантия и возврат
Frost
Коллекция Frost от производителя Royal Charm представлена роскошными блюдами, тарелками, салатниками, а также другой столовой посудой и предметами сервировки, изготовленными из прочного фарфора с глазурованным покрытием. Изделия имеют утонченный дизайн, оформленный в белых, зеленых или коричневых тонах, и превосходное качество исполнения. Отличительные особенности линейки – уникальная перламутровая глазурь и нежный цветочный узор, мерцающие изысканным сиянием, что придает предметам легкость и визуальную глубину. Посуда Frost станет элегантным украшением праздничной сервировки и подчеркнет ее статусность и индивидуальный характер. Три гармоничных цветовых решения позволяют создавать как универсальные, как и эффектные акцентные композиции. Изделия выдерживают интенсивное использование и легко очищаются от загрязнений вручную. Они станут идеальным выбором как для домашней сервировки, так и для подачи блюд в ресторанах и других профессиональных заведениях.
| Категория : | Тарелки |
| Производитель : | Royal Charm |
| Серия : | Frost |
| Страна : | Китай |
| Свойства : | Обеденные, Фарфоровые |
Отзывов нет...